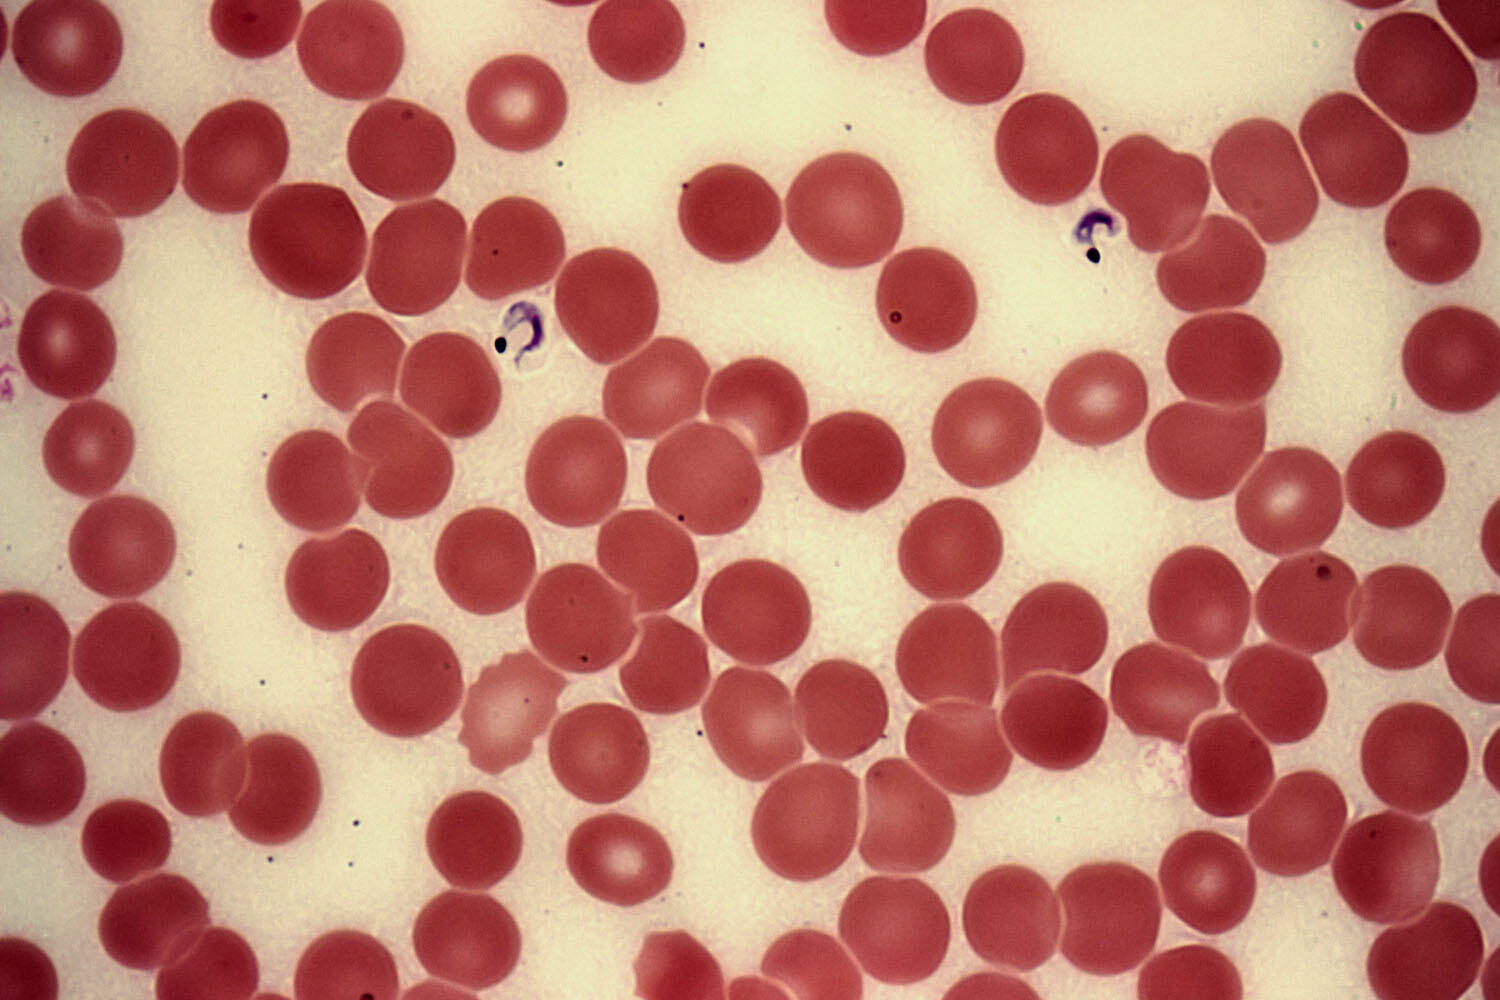
T. cruzi, the parasitic organism that causes Chagas disease, seen here in purple amid red blood cells. (Photo by Marc Perkins.) T. cruzi, the parasitic organism that causes Chagas disease, seen here in purple amid red blood cells. (Photo by Marc Perkins.)

“Keep a chorus of your mentors’ voices going inside your head, thereby permitting different perspectives and insights to come together in novel ways” is one of Charles Briggs’s “Principles for Unlearning,” which appear in Unlearning: Rethinking Poetics, Pandemics, and the Politics of Knowledge (2021, pp. 44-45). In his most recent book, the Berkeley anthropologist takes readers on an autobiographical journey through his multi-mentored scholarship. Central to this story, as the title suggests, is that Briggs’s academic career as an anthropologist has been one of unlearning, rethinking, and above all, experimenting with the very foundations of folkloristics, anthropology, and psychoanalysis.
It would be wrong, however, to say that Charles Briggs is the only author of this book. More than a monologue, what he offers in these pages is a particular kind of dialogue. He brings us on board right from the beginning to share a polyphonic space with peaches, 17th-century British scholars, mythical creatures, childhood friends, rainforest dwellers, wooden saints, and much more, to discuss (not without discomfort) the politics of knowledge, language, and health.
What stands out is that all these conversations are, in fact, deeply theoretical. Yet theory, here, is not only that which is integrated by the minds, mouths, pens, or keyboards of academic thinkers, but in practices of woodcarving, myth telling, healing, house building, and importantly, mourning. With his call “Theory is dead! Long live theory!” (2021, p. 62), Briggs emphasizes that this book is not about high theory, but about theory that matters, literally, as material.
He tells one of his mentorship stories: Silvianita and George López, artisanal woodcarvers in Cordova, New Mexico, taught Briggs that to do research about their trade, “a conversation between humans about objects” (2021, p. 23) would constitute an inadequate and politically uneven methodology. By refusing to be interviewed and throwing a chunk of wood and a carving knife at Briggs instead, the Lópezes made their point that the authority to write about carving had to be gained through an engagement with the materials and bodily dispositions of the trade. Thus, they reversed positions. Briggs was no longer the researcher, but the woodworkers’ apprentice. The Lópezes were no longer the research subjects, but Briggs’s teachers. Wood ceased to be an inanimate object that Briggs would simply act upon.
With a quote from master woodcarver David Esterly, Briggs (2021, p. 24) points out that, in carving, “(t)he wood is teaching you about itself, configuring your mind and muscles to the tasks required of them. To carve is to be shaped by the wood even as you’re shaping it.” By preventing the decoupling of carving from research, the Lópezes taught Briggs that academic knowledge production should not be severed from the work of caring for the objects, peoples, knowledges, and practices we become involved with through our research.
 |
Doing research with care is neither something new nor something with which only non-scientific practitioners can engage. Anthropologist Natasha Myers (2015) shows how “plant scientists learn to pay attention to what it is that plants pay attention to” (p. 42). In caring for what plants care about—soil pH and chemical composition, light gradients, temperature, etc.—the scientists must become intimately attuned to plants’ rhythms, shapes, and signs. Going further back in history, right at the epicenter of colonial natural sciences, Charles Darwin (1862, p. 235) compared the shapes of Catasetum, a particular genus of orchids to a man with his arms bent across his body in slightly different ways depending on each species. Myers (2015) speculates that Darwin might have had to position his body to mimic the different shapes of the Catasetum species he described.
Today’s scientists would condemn anthropomorphism as a flawed practice, but Myers wants to draw our attention to how, for Darwin, this learning process entailed letting his body become affected by the orchid. If we can imagine Darwin adopting the form of a plant with his body, we can realize that, rather than forcing human characteristics on plants, what is happening is a more complex process where learning requires that particular qualities of the body—shape and movement—become attached to the materiality of plants, at least for an instant (Myers, 2015, p. 58).
Theory, in this sense, is a relational endeavor and not one man’s abstract geniality. Theorizing is a practice that requires attending and participating in the material engagements of multiple things and beings as they act, perform, and speak for what they care about. In the words of philosopher of science Maria Puig de la Bellacasa, “here, care is mobilized to serve a gathering purpose: to hold together a thing and the publics concerned” (2017, p. 45).
I believe this holding together is part of the work of unlearning in which Briggs is inviting us to engage. For my part, as a physician who is trying to learn from anthropology’s sensitivities to human life, unlearning has taken up most of my space for academic engagement. Biomedicine (that is, so-called “Western” medicine) has been a major object of critique for the social sciences and humanities. Its disciplining power (Foucault, 1963/2003) has been mobilized to justify and enact racialization and enslavement practices (Spillers, 1987; Montoya, 2011), gender violence (Castro & Villanueva Lozano, 2018), and medical market abuses (Nguyen, 2010). Under the guise of scientific objectivity, many practitioners still refuse to take responsibility for the role that an individualistic view of health has in depoliticizing public health injustices (Metzl & Hansen, 2014).
Yet, it would be inaccurate to, first, see biomedicine as a totalizing monolith and, second, to deny that biomedical knowledge can be unequivocally beneficial. The question is then—to borrow the phrasing of science historian Michelle Murphy (2017)—how to think and work with and against biomedicine? How to hold together, in conversation, such divergent positions? Charles Briggs’s book gives us valuable insights into how this can be done in a way that does not take boundaries for granted but that moves across them at the same time that one works to understand how they are built and, if necessary, how to dismantle them. While there is so much to reflect on and say about this book, I will focus on one aspect that occupies my thoughts because it is in close relation to my research interests.
Notions of traditionality and modernity in public health and epidemic control demand we unlearn that the traditional and the modern are opposing extremes. The boundary between them is not always clearly drawn. Responding to decolonial scholar Walter Mignolo’s (2000) notion of the inter-implications of modernity and coloniality, Briggs draws attention to how traditionality is itself a modern object. Modernity envisions the impoverished, rural, female, and colonized subjects as trapped by tradition (Appadurai, 1988). This view allows modernity to inhabit a liberated space of unmarked human life, driven by reason and generalizable knowledge-making practices. It is in this sense that traditionality constitutes a central resource of colonial domination. Hence, as Briggs explains, it is problematic to think that traditionality exists beyond colonial power (2021, p. 101). In other words, traditionality and modernity are two sides of the same coin—a coin named coloniality.
An excellent example can be found in an earlier book Briggs co-authored with physician and epidemiologist Clara Mantini-Briggs, Stories in the Time of Cholera (2004). They narrate how, in the early 1990s, a cholera epidemic in Venezuela disproportionately affected Indigenous Warao people in the Orinoco Delta. Public health officials and the national media naturalized the fatal consequences of structural inequality by arguing that the Warao attachment to their traditions prevented them from complying with the modern principles of sanitation and hygiene. By making the Warao responsible for the deaths that cholera brought to their own communities, the state and the media redrew Venezuelan society along the lines of what Briggs and Mantini-Briggs (2004) refer to as “sanitary citizenship” (p. 9).

“Sanitary” citizens are those who abide by the norms and institutions of the biomedical model and are thus seen not only as less prone to disease, but also as deserving of basic rights and considerations. Those deemed “unsanitary” (like the Warao, in this case) might have these rights denied under the pretext that they are unwilling to, incapable of, or abusively accessing healthcare services—or that they pose a threat to public health altogether. Understanding how traditionality is mobilized to bolster structures of domination allows me to extend the exploration of this trinity of power—coloniality/modernity/traditionality—to other aspects of epidemiology and disease control.
The category of emerging infectious diseases responds to concerns about biosecurity. According to the U.S. Centers for Disease Control and Prevention, infectious diseases are considered emerging when “they have increased recently or are threatening to increase in the near future.” They can be “completely new” to the world, “completely new to an area,” “reappearing in an area,” or “caused by bacteria that have become resistant to antibiotics” (CDC, 2017).
The “newness”—that characteristic element of epidemio-logy and journalism’s temporalization practices (Briggs 2021, p. 248)—of the particular disease I work with (Chagas disease) is contested in the United States (Bern et al., 2019). The causal agent, the parasite Trypanosoma cruzi, is primarily transmitted via a blood-sucking insect vector, the triatomine or “kissing bug.” Mother-to-child, oral, and blood- and organ-donation transmission pathways have also been reported.
Early T. cruzi infection does not show characteristic early signs and symptoms, so it usually goes undetected at the initial stages. After 10 to 30 years, chronic damage to the structure of the heart and the digestive system becomes manifest and irreversible. While antiparasitic drugs should be provided to halt organ deterioration, effective treatment remains symptomatic. Affected individuals die of complications of heart failure, stroke, sudden cardiac arrest, and severe digestive malfunction.
Chagas disease is considered endemic to mainland Latin America, but the multispecies assemblages (Tsing, 2015) of T. cruzi, kissing bugs, humans, and other mammalian hosts have been historically present in the United States since before the land was so named (Reinhard et al., 2003). To date, scientists estimate that more than 300,000 migrants from Latin America are living with Chagas in the United States. They are assumed to have been infected in their home countries (Lynn et al., 2020). Data about Chagas disease acquired within the United States remains scarce, and only 41 such cases have been reported since 1955 (Bern et al., 2019).
Scientists point out that “in endemic areas, [triatomine bugs] infest traditional mud-walled human dwellings” (Klein et al., 2012, p. 1, my emphasis). In the United States, however, case reports point toward “non-traditional exposures” (Garcia et al., 2015, p. 327, my emphasis):
With higher standards of living in the United States, it is not surprising that vector exposure is more likely occurring by increased outdoor exposure. Camping and hunting are two outdoor exposure activities shown by our case reports as probable sources of infection (pp. 327-328).
Non-traditional exposures to T. cruzi are not those that occur among immigrants coming to the United States from Latin America, but among hikers, hunters, or rural homestead owners in the United States. In other words, humans hailing from south of the U.S. border, who have lived in rural areas, in close intimacy with animals identified as reservoirs, are the traditional and therefore naturalized subject of disease. In contrast, when the modern subjects—mainly wealthier White men—acquire the disease and become non-traditional cases, they raise the epidemiological alarm and thus activate the temporality of urgency. Here, we see another iteration of the traditionality/modernity/coloniality triad that organizes health politics across geographies and human and nonhuman bodies.
In her work on avian influenza, Celia Lowe relates how free-range chicken, once valued in the United States, rapidly became a pandemic threat with the emergence and swift propagation of the virus in Indonesia in 2003.
In associating backyard poultry production with ‘traditional, Asian’ agricultural practices, in contrast to modern commercial poultry production, ‘Asian culture’ itself became viewed by global health commentators as a potent source of risk. (Lowe, 2010, p. 638)
By contrast, in 2010, a 72-year-old White man from Texas who had tested positive for Chagas in blood-donation screening was told by his doctor “that his test results were ‘likely a false positive’ caused by his lack of Hispanic ethnicity and deferred further work-up and treatment” (Garcia et al., 2015, p. 327). In these two cases, rather than standing in clear opposition, modernity and traditionality find confluence in shifting notions of risk that differentially affect bodies enmeshed in the global networks of colonial power.
In a more recent instance of the mobilization of traditionality at the service of modernity, we can bring forth the ongoing calls to shut down the so-called “wet markets” in China and other southern countries (Latin America included), as well as the infamous derogatory humor of the almost-proverbial “bat soup” (Lynteris, 2020). Here, race, species, and their colonial underpinnings are channeled into efforts of domination through pathologization.

Yet, it is also problematic if a critique of the pathologization of tradition follows, as Briggs (2021) suggests, “… romantic notions of the nature of Indigenous and other subaltern identities that underlie some work in both postcolonial and decolonial studies” (p. 101). Siding with tradition as a morally superior position against modernity and coloniality may entail giving in to the “settler move to innocence” described by Tuck and Yang (2012): “… those strategies or positionings that attempt to relieve the settler of feelings of guilt or responsibility without giving up land or power or privilege, without having to change much at all” (p. 10). As a move to innocence, such enthusiasm for tradition may indicate a failure to engage with the complexities of what Briggs (2021) calls “traditionalization,” which he defines as “a process through which a broad range of cultural forms … are constructed so as to link them to the emergence of similar forms in the past” (p. 213). Such a focus on the past can “saturate cultural forms with affects and patterns of expectation that structure … how audiences engage with them.” Therefore, and responding to how different communities gather around things they care about, it can be said that traditionalization processes can be both “profoundly depoliticizing” (Briggs, 2021, p. 224), as well as capable of “repoliticizing cultural forms” (p. 225).
 |
Emerging infectious diseases do not occur without concomitant narrative and discursive dimensions that not only organize how epidemics develop in different communities but also how preventative and control measures are designed and deployed. As Briggs (2021) shows in Chapter 9 of Unlearning, when emerging infectious diseases become epidemic (and potentially pandemic), their propagation as a biosocial event is not free from the long-standing mediatization of outbreak narratives that manufacture an already-traditionalized epidemic space–time—what Russian philosopher and literary critic Mikhail Bakhtin (1981) would call a “chronotope”—characterized by “dramatic movements between types of spaces, actors, and types of narrative authority” (Briggs, 2021, p. 241).
This phenomenon is emphasized as well by the centrality of “newness” to epidemic temporality mentioned above. In Briggs’s words, “newness brings the distinct temporalization practices of journalism, virology, epidemiology, public health, and clinical medicine into alignment, turning [the new epidemic disease] into a boundary-object that fosters translatability and sparks shared ‘concern’” (Briggs, 2021, p. 249). Traditionalization of outbreak narratives, where stories about new, modern objects travel back and forth, from fiction to science, from journalism to government reports, evinces how narratives “do not simply report but make events” (Briggs, 2021, p. 241). In other words, there is a dialogic constitution of epidemic emergence at the intersection of genres, spaces, and actors (many of them nonhuman) that clash with one another to generate anxiety as the overarching affect.
Certain narratives about epidemics can become traditionalized and widely mediatized to serve the interests and perpetuation of dominant political-economic orders. That pathogens spill over, break out, or emerge from depoliticized and dehistoricized human–animal interfaces is one of these narratives. That knowledge about health and illness is solely produced in high centers of biomedical research and then trickles down unidirectionally (passing through government officials and health providers) to a purportedly passive larger society is another. These narratives leave aside the relevant role that human–nonhuman sociality and non-expert knowledge models play in the development of epidemics.
Studying epidemics then, requires paying attention not only to pathogen–host transmission, but moreover, to “the complex relations between the circulation of pathogens and discourse” (Briggs, 2021, p. 249, my emphasis), in short, what Briggs calls “biocommunicability.” A job that we social scientists and scholars in the humanities can take on in this regard is holding together the stories, narratives, and concerns that circulate and constitute epidemics as thoroughly social processes. After all, “everyone produces, circulates, and receives knowledge about the body, health, and disease” (Briggs, 2021, p. 208). This undertaking inevitably entails working with and against biomedicine’s discursive repertoire to find better ways to fare during epidemics, even as we challenge monopolizing attempts to theorize epidemics in ways that aim to secure colonial orders.
Bernardo Moreno Peniche is a Ph.D. student of Medical Anthropology at the UC Berkeley Anthropology Department and the UC San Francisco Department of Humanities and Social Sciences.
Deborah Meacham is the editor of the Berkeley Review of Latin American Studies.
References
Appadurai, A. (1988). Putting hierarchy in its place. Cultural Anthropology 3(1), 36–49. https://www.jstor.org/stable/656307?origin=JSTOR-pdf
Bakhtin, M. M. (1981). The Dialogic Imagination: Four Essays. Edited by Michael Holquist. Translated by Caryl Emerson and Michael Holquist. University of Texas Press.
Bern, C., Messenger, L. A., Whitman, J. D., & Maguire, J. H. (2019). Chagas disease in the United States: A public health approach. Clinical Microbiology Reviews 33(1). https://doi.org/10.1128/CMR.00023-19
Briggs, C. L. (2021). Unlearning: Rethinking poetics, pandemics, and the politics of knowledge. Utah State University Press.
Briggs, C. L., & Mantini-Briggs, C. (2004). Stories in the time of cholera: Racial profiling during a medical nightmare. University of California Press.
Castro, R., & Villanueva Lozano, M. (2018). Violencia en la práctica médica en México: Un caso de ambivalencia sociológica. Estudios sociológicos 36(108), 539–569.
Centers for Disease Control and Prevention (CDC). (2017, Aug 28). Who We Are | NCEZID | CDC. https://www.cdc.gov/ncezid/who-we-are/index.html
Darwin, C. (1862). On the various contrivances by which British and foreign orchids are fertilised by insects, and on the good effects of intercrossing. J. Murray.
Esterly, D. (2012). The lost carving: A journey to the heart of making. Viking.
Foucault, M. (2003) The birth of the clinic: An archeology of medical perception. Routledge. (Original work published in 1963)
Garcia, M. N., Aguilar, D., Gorchakov, R., Rossmann, S. N., Montgomery, S. P., Rivera, H., Woc-Colburn, L. Hotez, P. J., & Murray, K. O. (2015). Evidence of autochthonous Chagas disease in southeastern Texas. The American Journal of Tropical Medicine and Hygiene 92(2), 325–330. https://doi.org/10.4269/ajtmh.14-0238
Klein, N., Hurwitz, I., & Durvasula, R. (2012). Globalization of Chagas disease: A growing concern in nonendemic countries. Epidemiology Research International.
Lowe, C. (2010). Viral clouds: Becoming H5N1 in Indonesia. Cultural Anthropology 25(4), 625–49.
Lynn, M. K., Bossak, B. H., Sandifer, P. A., Watson, A., & Nolan, M. S. (2020 May). Contemporary autochthonous human Chagas disease in the USA. Acta Tropica 205. https://doi.org/10.1016/j.actatropica.2020.105361
Lynteris, C. (2020). Human extinction and the pandemic imaginary. Taylor & Francis.
Metzl, J. M., & Hansen, H. (2014). Structural competency: Theorizing a new medical engagement with stigma and inequality. Social Science & Medicine 103, 126–133.
Mignolo, W. D. (2000). Local histories/global designs: Coloniality, subaltern knowledges, and border thinking. Princeton University Press.
Montoya, M. (2011). Making the Mexican diabetic: Race, science, and the genetics of inequality. University of California Press.
Murphy, M. (2017). Reimagining chemicals with and against technoscience. Paper presented to the Department of Anthropology, History, and Social Medicine, University of California, San Francisco.
Myers, N. (2015). Conversations on plant sensing: Notes from the field. NatureCulture, 3, 35–66.
Nguyen, V-K. (2010). The republic of therapy: Triage and sovereignty in West Africa’s time of AIDS. Duke University Press.
Puig de la Bellacasa, M. (2017). Matters of care: Speculative ethics in more than human worlds. University of Minnesota Press.
Reinhard, K., Fink, T. M., & Skiles, J. (2003). A case of megacolon in Rio Grande Valley as a possible case of Chagas disease. Memorias do Instituto Oswaldo Cruz 98, (Suppl1)165–72.
Spillers, H. J. (1987). “Mama’s baby, papa’s maybe: An American grammar book.” Diacritics, 17(2), 64–81.
Tsing, A. L. (2015). The mushroom at the end of the world: On the possibility of life in capitalist ruins. Princeton University Press.
Tuck, E., & Yang, K. W. (2012). Decolonization is not a metaphor. Decolonization: Indigeneity, Education & Society 1, 1–40.

